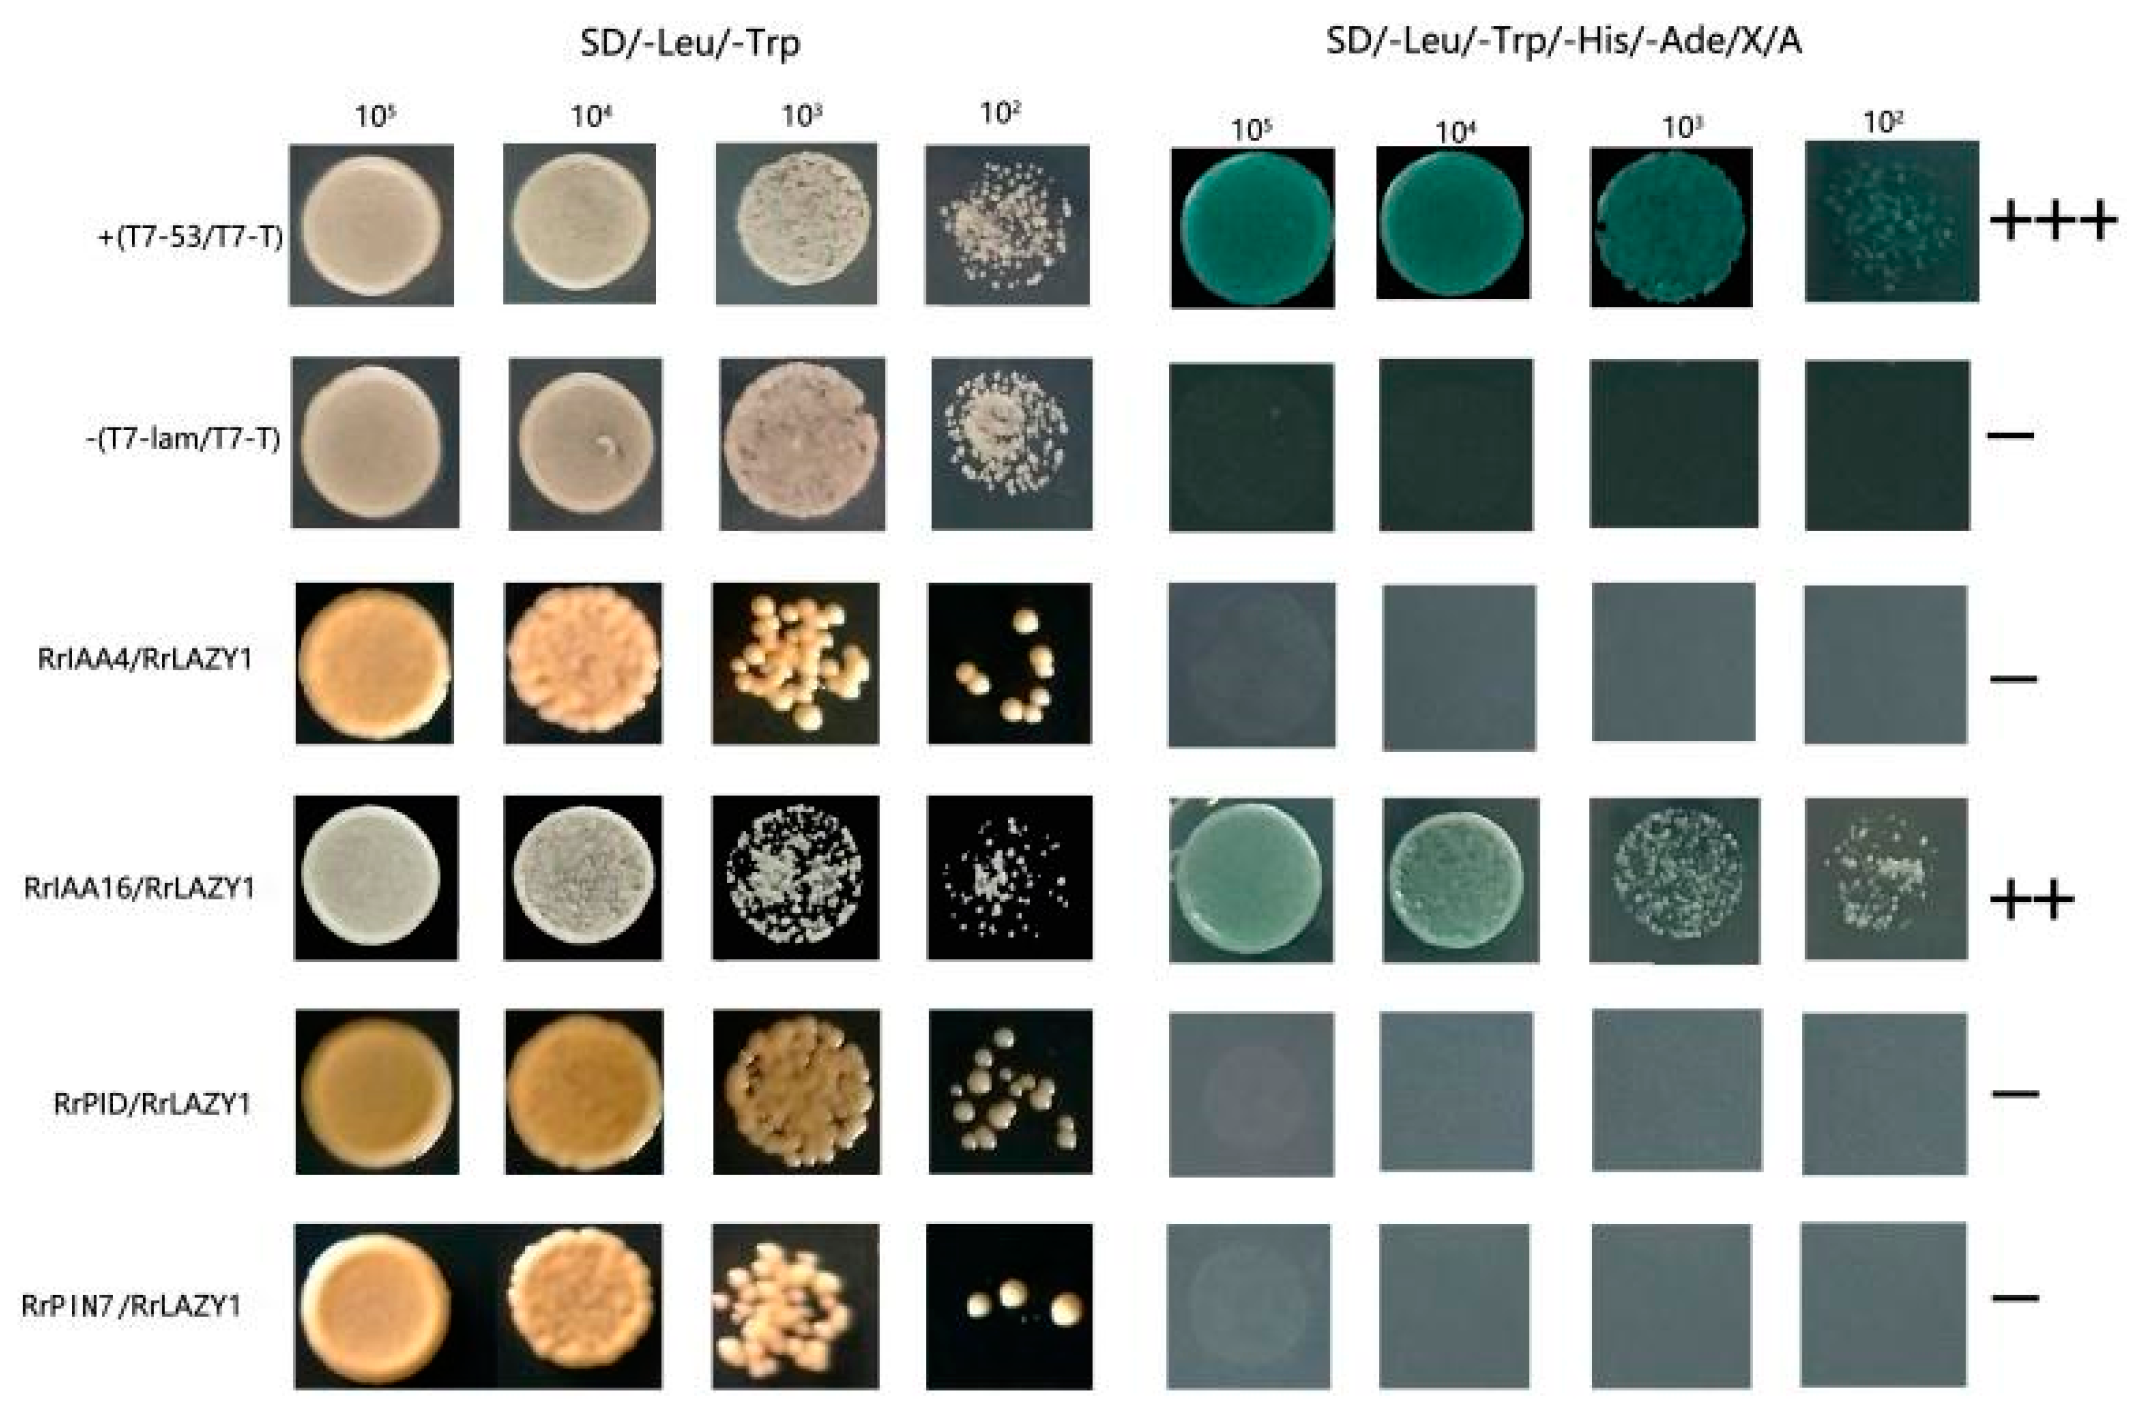
Ijms 22 13664 g006

Over-Expression of Rose RrLAZY1 Negatively Regulates the Branch Angle of Transgenic Arabidopsis Inflorescence
Abstract
:1. Introduction
2. Results
2.1. Cloning of RrLAZY1 and Sequence Analysis
2.2. Subcellular Localization of RrLAZY1
2.3. Expression Patterns of RrLAZY1 in Rosa
2.4. Identification of Transgenic Arabidopsis Plants
2.5. Phenotypic Observation of Transgenic Arabidopsis Plants
2.6. RrLAZY1 Interacts with Auxin Signaling Proteins
3. Discussion
4. Materials and Methods
4.1. Plant Materials
4.2. Total RNA Extraction and cDNA Synthesis
4.3. Gene Cloning and Sequence Analysis
4.4. Subcellular Localization of RrLAZY1
4.5. Identification and Phenotypic Observation of RrLAZY1 Transgenic Arabidopsis Plants
4.6. Expression Analysis via Quantitative RT-PCR
4.7. Yeast Two-Hybrid Assays
4.8. Bimolecular Fluorescence Complementation Experiment
4.9. Data Analysis
5. Conclusions
Supplementary Materials
Author Contributions
Funding
Institutional Review Board Statement
Informed Consent Statement
Data Availability Statement
Conflicts of Interest
References
- Sui, X.; Zhao, M.; Xu, Z.; Zhao, L.; Han, X. RrGT2, A Key Gene Associated with Anthocyanin Biosynthesis in Rosa rugosa, Was Identified Via Virus-Induced Gene Silencing and Overexpression. Int. J. Mol. Sci. 2018, 19, 4057. [Google Scholar] [CrossRef] [PubMed] [Green Version]
- Yang, M.; Zhao, L.Y. Research and classifification on the germplasm resources of the Pingyin Rosa rugosa in Shandong prov-ince. Landsc. Archit. J. Chin. 2003, 7, 61–63. [Google Scholar]
- Yu, S.C.; Feng, Z.; Zhao, L.Y. Research on quantitative taxonomy of cultivars in Pingyin rose. Acta Hortic. Sin. 2005, 32, 327–330. [Google Scholar]
- Yao, C.Y.; Ge, H.; Wu, H.; Jia, R.D.; Zhao, X.; Lv, Y.M.; Yang, S.H. Petal volatile components among different varieties of Rosa rugosa. Acta Hortic. Sin. 2019, 46, 375–384. [Google Scholar] [CrossRef]
- Li, Z.H. Cloning and Expression Analysis of LAZY1 Genes Related to Creeping Growth in Rosa rugosa. Master’s Thesis, Shandong Agricultural University, Tai’an, China, 2018. [Google Scholar]
- Xu, D.; Qi, X.; Li, J.; Han, X.; Wang, J.; Jiang, Y.; Tian, Y.; Wang, Y. PzTAC and PzLAZY from a narrow-crown poplar contribute to regulation of branch angles. Plant Physiol. Biochem. 2017, 118, 571–578. [Google Scholar] [CrossRef] [PubMed]
- Yu, B.S.; Lin, Z.W.; Li, H.X.; Li, X.J.; Li, J.Y.; Wang, Y.H.; Zhang, X.; Zhu, Z.F.; Zhai, W.X.; Wang, X.K.; et al. TAC1, a major quantitative trait locus controlling tiller angle in rice. Plant J. 2007, 52, 891–898. [Google Scholar] [CrossRef] [PubMed]
- Cao, X.; Deng, M.; Zhang, Z.L.; Liu, Y.J.; Yang, X.L.; Zhou, H. Molecular characterization and expression analysis of TaTAC1 gene in Triticum aestivum. J. Plant Genet. Resour. 2017, 18, 125–132. [Google Scholar]
- Ku, L.; Wei, X.; Zhang, S.; Zhang, J.; Guo, S.; Chen, Y. Cloning and Characterization of a Putative TAC1 Ortholog Associated with Leaf Angle in Maize (Zea mays L.). PLoS ONE 2011, 6, e20621. [Google Scholar] [CrossRef]
- Jiang, J.; Tan, L.; Zhu, Z.; Fu, Y.; Liu, F.; Cai, H.; Sun, C. Molecular Evolution of the TAC1 Gene from Rice (Oryza sativa L.). J. Genet. Genom. 2012, 39, 551–560. [Google Scholar] [CrossRef] [PubMed]
- Zhao, H.; Huai, Z.X.; Xiao, Y.J.; Wang, X.H.; Yu, J.Y.; Ding, G.D.; Peng, J.H. Natural variation and genetic analysis of the tiller angle gene MsTAC1 in Miscanthus sinensis. Planta 2014, 240, 161–175. [Google Scholar] [CrossRef] [PubMed]
- Dardick, C.; Callahan, A.; Horn, R.; Ruiz, K.B.; Zhebentyayeva, T.; Hollender, C.; Whitaker, M.; Abbott, A.; Scorza, R. PpeTAC1 promotes the horizontal growth of branches in peach trees and is a member of a functionally conserved gene family found in diverse plants species. Plant J. 2013, 75, 618–630. [Google Scholar] [CrossRef] [PubMed]
- Hollender, C.A.; Waite, J.M.; Tabb, A.; Raines, D.; Chinnithambi, S.; Dardick, C. Alteration of TAC1 expression in Prunus species leads to pleiotropic shoot phenotypes. Hortic. Res. 2018, 5, 1–9. [Google Scholar] [CrossRef] [PubMed] [Green Version]
- Li, H.; Sun, H.; Jiang, J.; Sun, X.; Tan, L.; Sun, C. TAC4 controls tiller angle by regulating the endogenous auxin content and distribution in rice. Plant Biotechnol. J. 2021, 19, 64–73. [Google Scholar] [CrossRef] [PubMed]
- Wu, X.; Tang, D.; Li, M.; Wang, K.; Cheng, Z. Loose Plant Architecture1, an Indeterminate Domain Protein Involved in Shoot Gravitropism, Regulates Plant Architecture in Rice. Plant Physiol. 2012, 161, 317–329. [Google Scholar] [CrossRef] [PubMed] [Green Version]
- Tan, L.B.; Li, X.R.; Liu, F.X.; Sun, X.Y.; Li, C.G.; Zhu, Z.; Fu, Y.; Cai, H.; Wang, X.K.; Xie, D.X. Control of a key transition from prostrate to erect growth in rice domestication. Nat. Genet. 2008, 40, 1360–1364. [Google Scholar] [CrossRef] [PubMed]
- Jin, J.; Huang, W.; Gao, J.-P.; Yang, J.; Shi, M.; Zhu, M.-Z.; Luo, D.; Lin, H.-X. Genetic control of rice plant architecture under domestication. Nat. Genet. 2008, 40, 1365–1369. [Google Scholar] [CrossRef] [PubMed]
- Zhu, M.; Hu, Y.J.; Tong, A.; Yan, B.; Lv, Y.; Wang, S.; Ma, W.; Cui, Z.; Wang, X. LAZY1 Controls Tiller Angle and Shoot Gravitropism by Regulating the Expression of Auxin Transporters and Signaling Factors in Rice. Plant Cell Physiol. 2020, 61, 2111–2125. [Google Scholar] [CrossRef] [PubMed]
- Qu, M.; Zhang, Z.; Liang, T.; Niu, P.; Wu, M.; Chi, W.; Chen, Z.-Q.; Chen, Z.-J.; Zhang, S.; Chen, S. Overexpression of a methyl-CpG-binding protein gene OsMBD707 leads to larger tiller angles and reduced photoperiod sensitivity in rice. BMC Plant Biol. 2021, 21, 1–14. [Google Scholar] [CrossRef] [PubMed]
- Hollender, C.A.; Dardick, C. Molecular basis of angiosperm tree architecture. New Phytol. 2015, 206, 541–556. [Google Scholar] [CrossRef] [PubMed] [Green Version]
- Hill, J.L.; Hollender, A.C. Branching out: New insights into the genetic regulation of shoot architecture in trees. Curr. Opin. Plant Biol. 2019, 47, 73–80. [Google Scholar] [CrossRef] [PubMed]
- Li, P.; Wang, Y.; Qian, Q.; Fu, Z.; Wang, M.; Zeng, D.; Li, B.; Wang, X.; Li, J. LAZY1 controls rice shoot gravitropism through regulating polar auxin transport. Cell Res. 2007, 17, 402–410. [Google Scholar] [CrossRef] [PubMed] [Green Version]
- Yoshihara, T.; Iino, M. Identification of the Gravitropism-Related Rice Gene LAZY1 and Elucidation of LAZY1-Dependent and -Independent Gravity Signaling Pathways. Plant Cell Physiol. 2007, 48, 678–688. [Google Scholar] [CrossRef] [PubMed] [Green Version]
- Yoshihara, T.; Spalding, E.P.; Iino, M. AtLAZY1 is a signaling component required for gravitropism of the Arabidopsis thalianainflorescence. Plant J. 2013, 74, 267–279. [Google Scholar] [CrossRef]
- Dong, Z.; Jiang, C.; Chen, X.; Zhang, T.; Ding, L.; Song, W.; Luo, H.; Lai, J.; Chen, H.; Liu, R.; et al. Maize LAZY1 Mediates Shoot Gravitropism and Inflorescence Development through Regulating Auxin Transport, Auxin Signaling, and Light Response. Plant Physiol. 2013, 163, 1306–1322. [Google Scholar] [CrossRef] [PubMed]
- Dong, Z.; Jin, W. Pleiotropic effects of ZmLAZY1 on the auxin-mediated responses to gravity and light in maize shoot and inflorescences. Plant Signal. Behav. 2013, 8, e27452. [Google Scholar] [CrossRef] [PubMed] [Green Version]
- Zhang, N.; Yu, H.; Yu, H.; Cai, Y.; Huang, L.; Xu, C.; Xiong, G.; Meng, X.; Wang, J.; Chen, H.; et al. A Core Regulatory Pathway Controlling Rice Tiller Angle Mediated by the LAZY1-Dependent Asymmetric Distribution of Auxin. Plant Cell 2018, 30, 1461–1475. [Google Scholar] [CrossRef] [PubMed] [Green Version]
- Taniguchi, M.; Furutani, M.; Nishimura, T.; Nakamura, M.; Fushita, T.; Iijima, K.; Baba, K.; Tanaka, H.; Toyota, M.; Tasaka, M.; et al. The Arabidopsis LAZY1 Family Plays a Key Role in Gravity Signaling within Statocytes and in Branch Angle Control of Roots and Shoots. Plant Cell 2017, 29, 1984–1999. [Google Scholar] [CrossRef] [Green Version]
- Hollender, C.A.; Hill, J.L.; Waite, J.; Dardick, C. Opposing influences of TAC1 and LAZY1 on Lateral Shoot Orientation in Arabidopsis. Sci. Rep. 2020, 10, 1–13. [Google Scholar] [CrossRef] [PubMed] [Green Version]
- Yoshihara, T.; Spalding, E.P. Switching the Direction of Stem Gravitropism by Altering Two Amino Acids in AtLAZY1. Plant Physiol. 2020, 182, 1039–1051. [Google Scholar] [CrossRef] [PubMed] [Green Version]
- Muranen, S. Function of LAZY1a in Silver Birch (Betula pendula). Master’s Thesis, University of Helsinki Faculty of Biological and Environmental Sciences Plant Molecular Biology, Helsinki, Finland, 2019. [Google Scholar]
- Zhang, X.-Q.; Wang, X.-W.; Tian, W.-J.; Sun, Y.; Li, Y.-Y.; Xie, J.; He, G.-H.; Sang, X.-C. LAZY1 Regulates Development of Rice Leaf Angle through Brassinolide Pathway. Acta Agron. Sin. 2017, 43, 1767–1773. [Google Scholar] [CrossRef]
- Xia, X.; Mi, X.; Jin, L.; Guo, R.; Zhu, J.; Xie, H.; Liu, L.; An, Y.; Zhang, C.; Wei, C.; et al. CsLAZY1 mediates shoot gravitropism and branch angle in tea plants (Camellia sinensis). BMC Plant Biol. 2021, 21, 1–12. [Google Scholar] [CrossRef] [PubMed]
- Zhang, L.; Ye, Z.W.; Zhao, C.X.; Zhang, G.S.; Yang, H.F. Cloning and Bioinformatics analysis of SpsLAZY1a and SpsLAZY1b genes in Salix psammophila. J. Northwest For. Univ. 2017, 32, 98–105. [Google Scholar] [CrossRef]
- Li, Z.; Liang, Y.; Yuan, Y.; Wang, L.; Meng, X.; Xiong, G.; Zhou, J.; Cai, Y.; Han, N.; Hua, L.; et al. OsBRXL4 Regulates Shoot Gravitropism and Rice Tiller Angle through Affecting LAZY1 Nuclear Localization. Mol. Plant 2019, 12, 1143–1156. [Google Scholar] [CrossRef] [PubMed]
- Yoshihara, T.; Spalding, E.P. LAZY Genes Mediate the Effects of Gravity on Auxin Gradients and Plant Architecture. Plant Physiol. 2017, 175, 959–969. [Google Scholar] [CrossRef] [PubMed] [Green Version]
- Zhang, X.; Lin, Z.; Wang, J.; Liu, H.; Zhou, L.; Zhong, S.; Li, Y.; Zhu, C.; Liu, J.; Lin, Z. The tin1 gene retains the function of promoting tillering in maize. Nat. Commun. 2019, 10, 1–13. [Google Scholar] [CrossRef] [PubMed] [Green Version]

Publisher’s Note: MDPI stays neutral with regard to jurisdictional claims in published maps and institutional affiliations. |
© 2021 by the authors. Licensee MDPI, Basel, Switzerland. This article is an open access article distributed under the terms and conditions of the Creative Commons Attribution (CC BY) license (https://creativecommons.org/licenses/by/4.0/).
Share and Cite
Li, D.; Zhao, M.; Yu, X.; Zhao, L.; Xu, Z.; Han, X. Over-Expression of Rose RrLAZY1 Negatively Regulates the Branch Angle of Transgenic Arabidopsis Inflorescence. Int. J. Mol. Sci. 2021, 22, 13664. https://doi.org/10.3390/ijms222413664
Li D, Zhao M, Yu X, Zhao L, Xu Z, Han X. Over-Expression of Rose RrLAZY1 Negatively Regulates the Branch Angle of Transgenic Arabidopsis Inflorescence. International Journal of Molecular Sciences. 2021; 22(24):13664. https://doi.org/10.3390/ijms222413664
Chicago/Turabian StyleLi, Dan, Mingyuan Zhao, Xiaoyan Yu, Lanyong Zhao, Zongda Xu, and Xu Han. 2021. "Over-Expression of Rose RrLAZY1 Negatively Regulates the Branch Angle of Transgenic Arabidopsis Inflorescence" International Journal of Molecular Sciences 22, no. 24: 13664. https://doi.org/10.3390/ijms222413664
APA StyleLi, D., Zhao, M., Yu, X., Zhao, L., Xu, Z., & Han, X. (2021). Over-Expression of Rose RrLAZY1 Negatively Regulates the Branch Angle of Transgenic Arabidopsis Inflorescence. International Journal of Molecular Sciences, 22(24), 13664. https://doi.org/10.3390/ijms222413664
